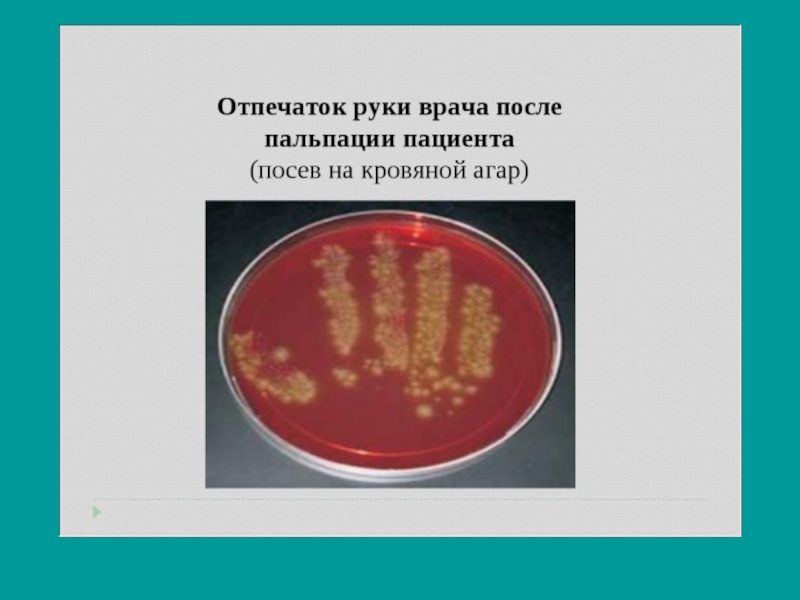

Ю.Е.
- Главная
- Разное
- Образование
- Спорт
- Естествознание
- Природоведение
- Религиоведение
- Французский язык
- Черчение
- Английский язык
- Астрономия
- Алгебра
- Биология
- География
- Геометрия
- Детские презентации
- Информатика
- История
- Литература
- Математика
- Музыка
- МХК
- Немецкий язык
- ОБЖ
- Обществознание
- Окружающий мир
- Педагогика
- Русский язык
- Технология
- Физика
- Философия
- Химия
- Шаблоны, фоны, картинки для презентаций
- Экология
- Экономика
Презентация, доклад на тему Обработка рук медицинского персонала
Содержание
- 1. Обработка рук медицинского персонала
- 2. Известно, что на коже рук всегда в
- 3. Руки – это «медицинский инструмент» , которым
- 4. Правильная и своевременная обработка рук является залогом безопасности медицинского персонала и пациентов.
- 5. Руки являются одним из основных
- 6. Обработка рук делится на три уровня: Бытовой
- 7. Механическая обработка рук. Цель бытового уровня обработки
- 8. Основные показания для мытья рук.Обычное мытье рук
- 9. Правила обработки рук:Снимаются с рук все украшения,
- 10. Слайд 10
- 11. Гигиеническая обработка рукЦель гигиенической обработки — уничтожение микрофлоры кожи при помощи антисептиков (дезинфекция).
- 12. Гигиеническая антисептика рук обязательно требуется:Перед выполнением инвазивных
- 13. Слайд 13
- 14. Антисептики для рук.Антисептики для обработки рук должны
- 15. Слайд 15
- 16. Таким образом, гигиена рук является неотъемлемой частью
- 17. Спасибо за внимание! Следите за чистотой своих рук.
Известно, что на коже рук всегда в том или ином количестве присутствует микрофлора , т.е микроорганизмы. 1 см2 кожи содержит 100 - 1000 бактерий.
Слайд 1Обработка рук медицинского персонала.
Работу выполнила:
Студентка 2 курса 212 группы
Травина Антонина
Преподаватель:
Николаева
Слайд 2Известно, что на коже рук всегда в том или ином количестве
присутствует микрофлора , т.е микроорганизмы. 1 см2 кожи содержит 100 - 1000 бактерий.
Слайд 3Руки – это «медицинский инструмент» , которым персонал пользуется чаще всего.
Но в отличие от обычных медицинских инструментов, руки не могут быть полностью лишены микробов и поэтому их дезинфекция постоянно необходима во время работы.
Слайд 4Правильная и своевременная обработка рук является залогом безопасности медицинского персонала и
пациентов.
Слайд 5
Руки являются одним из основных факторов передачи возбудителей ВБИ.
Через руки персонала передаётся транзиторная патогенная или условно-патогенная микрофлора и микроорганизмы. Дезинфекция рук является одной из самых эффективных мер по предупреждению ВБИ и по защите пациентов и медицинского персонала от инфицирования. Основа профилактики ВБИ – гигиеническая культура.
Слайд 6Обработка рук делится на три уровня:
Бытовой уровень (механическая обработка рук)
Гигиенический уровень (обработка рук с применением кожных антисептиков )
Хирургический уровень (особая последовательность манипуляций при обработке рук с последующим одеванием стерильных перчаток)
Слайд 7Механическая обработка рук. Цель бытового уровня обработки рук — механическое удаление с
кожи большей части микрофлоры (антисептики не применяются).
Слайд 8Основные показания для мытья рук.
Обычное мытье рук с мылом обязательно требуется:
Перед
и после физического контакта с пациентом
Перед приготовлением и раздачей пищи, перед едой
После выполнения определенных функций собственного организма (посещение туалета, сморкание и т.п.)
Во всех случаях, когда руки явно загрязнены
Перед приготовлением и раздачей пищи, перед едой
После выполнения определенных функций собственного организма (посещение туалета, сморкание и т.п.)
Во всех случаях, когда руки явно загрязнены
Слайд 9Правила обработки рук:
Снимаются с рук все украшения, часы, поскольку они затрудняют
удаление микроорганизмов.
Руки намыливаются, затем ополаскиваются тёплой проточной водой и всё повторяется сначала. Считается, что при первом намыливании и ополаскивании тёплой водой микробы смываются с кожи рук. Под воздействием тёплой воды и самомассажа поры кожи открываются, поэтому при повторном намыливании и ополаскивании смываются микробы из раскрывшихся пор.
Руки намыливаются, затем ополаскиваются тёплой проточной водой и всё повторяется сначала. Считается, что при первом намыливании и ополаскивании тёплой водой микробы смываются с кожи рук. Под воздействием тёплой воды и самомассажа поры кожи открываются, поэтому при повторном намыливании и ополаскивании смываются микробы из раскрывшихся пор.
Слайд 11Гигиеническая обработка рук
Цель гигиенической обработки — уничтожение микрофлоры кожи при помощи
антисептиков (дезинфекция).
Слайд 12Гигиеническая антисептика рук обязательно требуется:
Перед выполнением инвазивных процедур
Перед работой с
особо восприимчивыми пациентами и новорожденными
Перед и после манипуляций с ранами, катетерами
Перед и после надевания перчаток
После контакта с выделениями и предметами, содержащими кровь или имеющими вероятность микробной контаминации (например, осмотр инфицированного пациента, измерение ректальной температуры)
Перед и после манипуляций с ранами, катетерами
Перед и после надевания перчаток
После контакта с выделениями и предметами, содержащими кровь или имеющими вероятность микробной контаминации (например, осмотр инфицированного пациента, измерение ректальной температуры)
Слайд 14Антисептики для рук.
Антисептики для обработки рук должны отвечать сразу нескольким параметрам.
Препарат должен не только обладать широким спектром антимикробного действия и максимально уменьшать количество микроорганизмов на коже, но и, что очень важно, не вызывать раздражения и аллергических реакций.
Слайд 16Таким образом, гигиена рук является неотъемлемой частью системы мер по профилактике
внутрибольничной инфекции в лечебной организации.